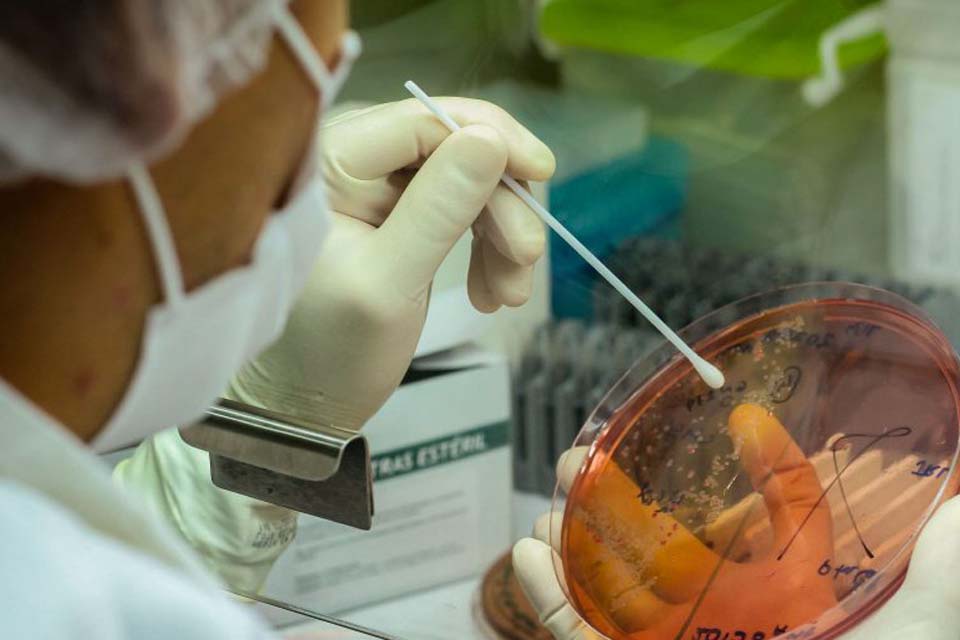

Por Mineia Capistrano/Secom
Publicada em 28/09/2020 às 12h24
Confirmando a tendência que se esperava, o Estado de Rondônia bateu neste sábado (25), a marca dos 200 mil testes realizados, consolidando sua posição entre os que mais se esforçam na realização desses exames fundamentais para diagnosticar a Covid-19 em todo o País, conforme indicação do Boletim Covid-19, edição 192, divulgado neste Portal, que registrou 201.010 testes desde o começo da pandemia.
Conforme explicações do secretário de saúde, Fernando Máximo, é preciso creditar esta performance do Estado de Rondônia à determinação do governador Marcos Rocha, que incentivou e participou pessoalmente da realização de várias iniciativas para envolver e proteger a população, como na realização de drive-thru para realização de testes e exames para diagnosticar a doença, assim como a ação fundamental do Laboratório Central de Saúde Pública de Rondônia (Lacen), que é referência na região Norte do País, e responsável pelos exames e diagnóstico de pacientes infectados pelo coronavírus no Estado, com capacidade para realizar mais de 1.500 testes diários.
“A decisão de adotar sempre as melhores medidas para enfrentar a Covid-19 foi fundamental em nosso trabalho”, disse Fernando Máximo, destacando a importância de se antecipar providências (medicar) antes de sua manifestação plena, resultado das ações de testagem por meio do drive-thru, que ajudaram acelerar todas as medidas de combate à doença. Ele destacou também o conjunto das medidas de proteção adotadas pelo Governo, o profissionalismo dos servidores da saúde, e a ação sempre pronta e segura do Lacen, que foi e está sendo fundamental em todas as fases do trabalho contra a Covid-19, e tem capacidade para realizar mais de 1.500 testes diários.
Há vários meses o Estado de Rondônia figura em primeiro lugar no Portal da Transparência da Covid-19
TRANSPARÊNCIA
Da mesma forma, como vem se repetindo nos últimos meses, Rondônia continua em destaque como um dos estados com maior nível de desempenho no Portal da Transparência, no ranking de melhor divulgação de dados da Covid-19. O governador Marcos Rocha disse que o Estado se mantém vigilante nos cuidados e medidas de prevenção e controle da doença e também na divulgação plena de todos os dados relativos a ela. Para ele, apesar de todas as dificuldades, é uma satisfação ver que os esforços da equipe de saúde nesta jornada pela população e em defesa da vida vem dando bons resultados.
O desempenho de Rondônia tanto no programa de testagem como na divulgação dos dados sobre a Covid-19 no Portal da Transparência vem se repetindo há vários meses, entre os primeiros colocados, o que revela o esforço do Governo do Estado no enfrentamento e controle da doença, que passou a exigir o máximo empenho das autoridades da saúde e significativos investimentos para contratação de pessoal, aquisição de insumos e equipamentos de proteção.
No Portal Transparência de Rondônia, que pode ser acessado no endereço http://www.transparencia.ro.gov.br/ é possível obter todas as informações do Estado sobre licitações, compras emergenciais, e todas as ações governamentais para atender aos diversos órgãos em suas necessidades para o enfrentamento Covid-19, contemplando também o conjunto das informações sobre aquisição de leitos hospitalares, licitação e contratação de obras e serviços, hospitais de campanha e os procedimentos para a compra de uma unidade hospitalar inteira para atender a demanda gerada pela disseminação do novo coronavírus.
Para Fernando Máximo, o alto desempenho da gestão estadual nesta área, principalmente, reconhecido nacionalmente, é o resultado do empenho e esforço de todos contra a doença e motivo de satisfação para o Governo do Estado.

 imprimir
imprimir













